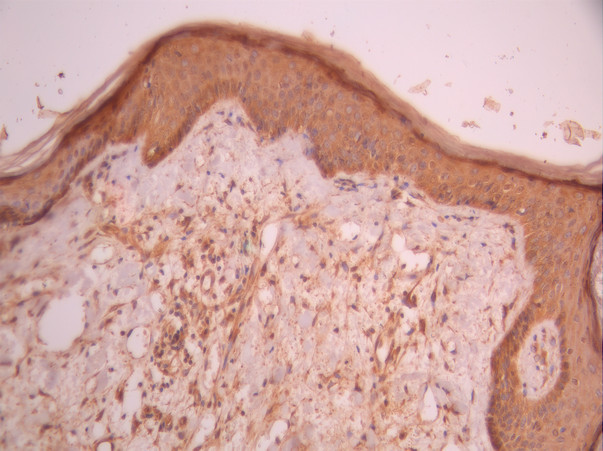

-
中文名稱:AKT1S1 Recombinant Monoclonal Antibody
-
貨號:CSB-RA131536A0HU
-
規格:¥1320
-
圖片:
-
IHC image of CSB-RA131536A0HU diluted at 1:100 and staining in paraffin-embedded human skin tissue performed on a Leica BondTM system. After dewaxing and hydration, antigen retrieval was mediated by high pressure in a citrate buffer (pH 6.0). Section was blocked with 10% normal goat serum 30min at RT. Then primary antibody (1% BSA) was incubated at 4°C overnight. The primary is detected by a Goat anti-rabbit polymer IgG labeled by HRP and visualized using 0.05% DAB.
-
IHC image of CSB-RA131536A0HU diluted at 1:100 and staining in paraffin-embedded human breast cancer performed on a Leica BondTM system. After dewaxing and hydration, antigen retrieval was mediated by high pressure in a citrate buffer (pH 6.0). Section was blocked with 10% normal goat serum 30min at RT. Then primary antibody (1% BSA) was incubated at 4°C overnight. The primary is detected by a Goat anti-rabbit polymer IgG labeled by HRP and visualized using 0.05% DAB.
-
Overlay Peak curve showing Hela cells stained with CSB-RA131536A0HU (red line) at 1:100. The cells were fixed in 4% formaldehyde and permeated by 0.2% TritonX-100 for 10min. Then 10% normal goat serum to block non-specific protein-protein interactions followed by the antibody (1ug/1*106cells) for 45min at 4℃. The secondary antibody used was FITC-conjugated goat anti-rabbit IgG (H+L) at 1/200 dilution for 35min at 4℃.Control antibody (green line) was Rabbit IgG (1ug/1*106cells) used under the same conditions. Acquisition of >10, 000 events was performed.
-
-
其他:
產品詳情
-
Uniprot No.:
-
基因名:
-
別名:40 kDa proline rich AKT substrate antibody; 40 kDa proline-rich AKT substrate antibody; AKT1 S1 antibody; AKT1 substrate 1 (proline rich) antibody; AKT1 substrate 1 antibody; AKT1S 1 antibody; AKT1S1 antibody; AKTS1_HUMAN antibody; Lobe antibody; MGC2865 antibody; PRAS 40 antibody; PRAS antibody; PRAS40 antibody; Proline rich akt substrate antibody; Proline rich Akt substrate 40 kDa antibody; Proline-rich AKT1 substrate 1 antibody
-
反應種屬:Human
-
免疫原:A synthesized peptide from human AKT1S1 protein
-
免疫原種屬:Homo sapiens (Human)
-
標記方式:Non-conjugated
-
克隆類型:Monoclonal
-
抗體亞型:Rabbit IgG
-
純化方式:Affinity-chromatography
-
克隆號:17A2
-
濃度:It differs from different batches. Please contact us to confirm it.
-
保存緩沖液:Rabbit IgG in 10mM phosphate buffered saline , pH 7.4, 150mM sodium chloride, 0.05% BSA, 0.02% sodium azide and 50% glycerol.
-
產品提供形式:Liquid
-
應用范圍:ELISA, IHC, FC
-
推薦稀釋比:
Application Recommended Dilution IHC 1:50-1:200 FC 1:50-1:200 -
Protocols:
-
儲存條件:Upon receipt, store at -20°C or -80°C. Avoid repeated freeze.
-
貨期:Basically, we can dispatch the products out in 1-3 working days after receiving your orders. Delivery time maybe differs from different purchasing way or location, please kindly consult your local distributors for specific delivery time.
-
用途:For Research Use Only. Not for use in diagnostic or therapeutic procedures.
相關產品
靶點詳情
-
功能:Subunit of mTORC1, which regulates cell growth and survival in response to nutrient and hormonal signals. mTORC1 is activated in response to growth factors or amino acids. Growth factor-stimulated mTORC1 activation involves a AKT1-mediated phosphorylation of TSC1-TSC2, which leads to the activation of the RHEB GTPase that potently activates the protein kinase activity of mTORC1. Amino acid-signaling to mTORC1 requires its relocalization to the lysosomes mediated by the Ragulator complex and the Rag GTPases. Activated mTORC1 up-regulates protein synthesis by phosphorylating key regulators of mRNA translation and ribosome synthesis. mTORC1 phosphorylates EIF4EBP1 and releases it from inhibiting the elongation initiation factor 4E (eiF4E). mTORC1 phosphorylates and activates S6K1 at 'Thr-389', which then promotes protein synthesis by phosphorylating PDCD4 and targeting it for degradation. Within mTORC1, AKT1S1 negatively regulates mTOR activity in a manner that is dependent on its phosphorylation state and binding to 14-3-3 proteins. Inhibits RHEB-GTP-dependent mTORC1 activation. Substrate for AKT1 phosphorylation, but can also be activated by AKT1-independent mechanisms. May also play a role in nerve growth factor-mediated neuroprotection.
-
基因功能參考文獻:
- The Akt-PRAS40 pathway is activated by uric acid, which inhibits autophagy and recapitulates the uric acid-induced proinflammatory cytokine phenotype. PMID: 28484006
- crystal structures of RAPTOR-TOS motif complexes that define the determinants of TOS recognition, of an mTOR FKBP12-rapamycin-binding (FRB) domain-substrate complex that establishes a second substrate-recruitment mechanism, and of a truncated mTOR-PRAS40 complex that reveals PRAS40 inhibits both substrate-recruitment sites PMID: 29236692
- Study found that activated PRAS40 acts not only as a regulator of TGFA-triggered exosome secretion but also as a common regulator of distinct microenvironmental and oncogenic signal-triggered exosome secretion in both normal and tumor cell types. PRAS40 is the first regulator identified for stress-induced exosome secretion. PMID: 28674187
- PRAS40 was downregulated in the DU145 cells following MYO6 knockdown. PMID: 27431378
- Phosphorylation of S202/203 of AKT1S1 by PKM2 released AKT1S1 from raptor and facilitated its binding to 14-3-3, resulted in hormonal- and nutrient-signals independent activation of mTORC1 signaling and led accelerated oncogenic growth and autophagy inhibition in cancer cells. PMID: 26876154
- The frameshift mutation detected in the current study would result in a premature stop of amino-acid synthesis in AKT1S1 protein and hence resembles a typical loss-of-function mutation. PMID: 25648575
- Supporting this idea, we identified a downstream target of the TGFb-miR-96 signaling pathway to be AKT1S1 mRNA, whose translated protein is a negative regulator of mTOR kinase. PMID: 25531317
- This review discusses the role of PRAS40 and possible feedback mechanisms, and alterations in AKT/PRAS40/mTOR signaling that have been implicated in the pathogenesis of tumor progression. [review] PMID: 26003731
- Findings indicate that dual phosphorylation of PRAS40 by Akt and mTORC1 promotes formation of a nuclear-specific PRAS40- and RPL11-containing complex distinct from mTORC1 that inhibits the RPL11-HDM2-p53 pathway. PMID: 24704832
- PRAS40 as a regulator of insulin sensitivity in hSkMC PMID: 24576065
- PRAS40 contains a functional nuclear export signal. Furthermore, enforced nuclear accumulation of PRAS40 impairs insulin action, thereby substantiating the function of this protein in the regulation of insulin sensitivity. PMID: 23712034
- Data suggest that PRAS40 modulates insulin action in skeletal muscle; knockdown of PRAS40 inhibits insulin action in cultured myotubes and is associated with up-regulation of IRS1 (insulin receptor substrate 1) degradation via proteasome proteolysis. PMID: 23460019
- WISP1 governs PRAS40 by sequestering PRAS40 intracellularly through post-translational phosphorylation. PMID: 22873724
- study found tuberin and PRAS40 to be potent anti-apoptotic gatekeepers in early stem-cell differentiation; data allow new insights into the regulation of early stem-cell maintenance and differentiation and identify a new role of the tumor suppressor tuberin and the oncogenic protein PRAS40 PMID: 22090422
- This review summarizes the regulation and potential function(s) of PRAS40 in the complex Akt- and mTOR-signaling network in health and disease--{REVIEW} PMID: 22354785
- our findings suggest that PRAS40 promotes the development of ESFT PMID: 22241085
- PRAS40 is known for its ability to regulate the mammalian target of rapamycin complex 1 kinase activity, possessing a key regulatory role at the cross point of signal transduction pathways activated by growth factor receptors PMID: 21906675
- phosphorylation of PRAS40 is critical for the activation of mTOR in CNI-induced VEGF overexpression and renal cancer progression. PMID: 21886838
- dissociation of PRAS40 from insulin-stimulated 4E-BP protein binding to mTORC1 and enhanced mTORC1 substrate binding results from Akt and mTORC1 activation and makes little or no contribution to mTORC1 signaling PMID: 21914810
- PIM1-activated pPRAS40, AKT-activated pFOXO3a, and their complex formation with 14-3-3 could be key regulators of the radiation-induced radioresistance in NSCLC cells PMID: 21910584
- PRAS40 is an important regulator of insulin sensitivity of the Akt-mTOR pathway and a potential target for the treatment of cancers, insulin resistance and hamartoma syndromes. PMID: 17277771
- PRAS40 inhibits cell growth, S6K1 phosphorylation, and rheb-induced activation of the mTORC1 pathway PMID: 17386266
- PRAS40 regulates mTORC1 kinase activity by functioning as a direct inhibitor of substrate binding. PMID: 17510057
- PRAS40 acts downstream of mTORC1 but upstream of its effectors, such as S6K1 and 4E-BP1 PMID: 17604271
- activation of mTORC1 signalling by phorbol esters does not require PRAS40 to be phosphorylated at Thr(246), bind to 14-3-3 or be released from mTORC1. PMID: 18215133
- after mTORC1 kinase activation by upstream regulators, PRAS40 is phosphorylated directly by mTOR, thus contributing to the relief of PRAS40-mediated substrate competition. PMID: 18372248
顯示更多
收起更多
-
亞細胞定位:Cytoplasm, cytosol.
-
組織特異性:Widely expressed with highest levels of expression in liver and heart. Expressed at higher levels in cancer cell lines (e.g. A-549 and HeLa) than in normal cell lines (e.g. HEK293).
-
數據庫鏈接:
Most popular with customers
-
-
YWHAB Recombinant Monoclonal Antibody
Applications: ELISA, WB, IHC, IF, FC
Species Reactivity: Human, Mouse, Rat
-
Phospho-YAP1 (S127) Recombinant Monoclonal Antibody
Applications: ELISA, WB, IHC
Species Reactivity: Human
-
-
-
-
-